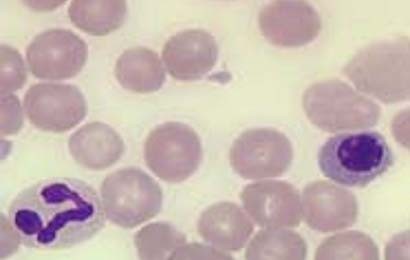

Agranulocytosis merupakan kegagalan tulang sunsum untuk membuat sel darah putih yang cukup. Tulang sunsum merupakan jaringan lembut di dalam tulang yang membentuk sel darah. Penyebab Agranulocytosis adalah seseorang kurang memiliki tipe sel darah putih, yang disebut neutrophils atau granulocytes. Rendahnya neutrophil memungkinkan juga terjadinya sel darah putih diserang lebih cepat ketimbang dari produksinya.
Gejala
Seseorang yang mengidap penyakit ini mudah terinfeksi.
Pengobatan
Pengobatan untuk agranulocytosis berdasarkan entiologi. Pada banyak kasus, pengobatan untuk penyakit ini rumit. Namun langkah yang lebih penting adalah untuk menghentikan perulangan serangan. Jika keterangan penyebab tidak diketahui, para medis biasanya menghentikan pemberian obat sampai etiologi yang adekuat.
ADVERTISEMENT
SCROLL TO CONTINUE WITH CONTENT
(tbs/tbs)